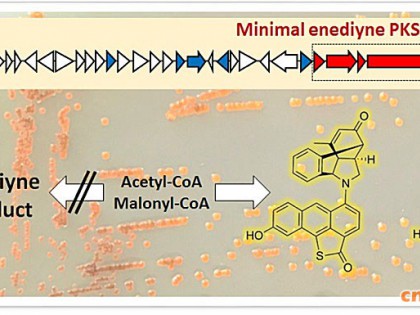

医药
-
医药1512
-
医药2153
-
医药1574
-
医药1227
-
医药4596
-
医药1202
-
医药1400
-
医药1699
-
医药2402
-
医药1389
-
医药4044
-
医药1143
-
医药2492
-
医药2368
-
医药1930
-
医药566
-
医药1547
-
医药2697
发酵工业网手机版
打开微信右上角添加朋友中搜索公众号“发酵工业”,关注即可随时随地使用发酵工业服务。发酵工业微信更省心!